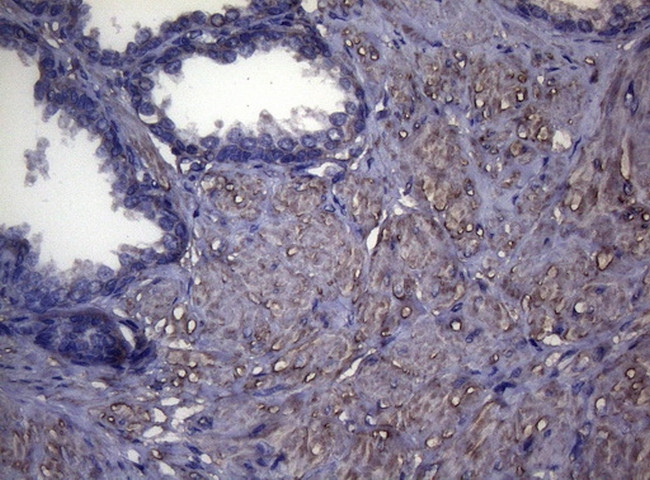
MAK Antibody in Immunohistochemistry (Paraffin) (IHC (P))

Search
OriGene
MAK Monoclonal Antibody (OTI5A7), TrueMAB™
{{$productOrderCtrl.translations['antibody.pdp.commerceCard.promotion.promotions']}}
{{$productOrderCtrl.translations['antibody.pdp.commerceCard.promotion.viewpromo']}}
{{$productOrderCtrl.translations['antibody.pdp.commerceCard.promotion.promocode']}}: {{promo.promoCode}} {{promo.promoTitle}} {{promo.promoDescription}}. {{$productOrderCtrl.translations['antibody.pdp.commerceCard.promotion.learnmore']}}
产品信息
CF808843
种属反应
宿主/亚型
分类
类型
克隆号
抗原
偶联物
形式
浓度
纯化类型
保存液
内含物
保存条件
运输条件
产品详细信息
For reconstitution, we recommend adding 100 µL distilled water to a final antibody concentration of about 1 mg/mL. To use this carrier-free antibody for conjugation experiments, we strongly recommend performing another round of desalting. (Zeba Spin Desalting Columns, 7KMWCO, 0.5 mL, Product # 89882)
靶标信息
The product of this gene is a serine/threonine protein kinase related to kinases involved in cell cycle regulation. It is expressed almost exclusively in the testis, primarily in germ cells. Studies of the mouse and rat homologs have localized the kinase to the chromosomes during meiosis in spermatogenesis, specifically to the synaptonemal complex that exists while homologous chromosomes are paired. There is, however, a study of the mouse homolog that has identified high levels of expression in developing sensory epithelia so its function may be more generalized.
仅用于科研。不用于诊断过程。未经明确授权不得转售。
篇参考文献 (0)
生物信息学
蛋白别名: dJ417M14.2; Male germ cell-associated kinase; male germ cell-associated kinase retinal-enriched isoform; serine/threonine protein kinase MAK; Serine/threonine-protein kinase MAK; testicular secretory protein Li 28
基因别名: MAK; RP62
UniProt ID: (Human) P20794, (Rat) P20793
Entrez Gene ID: (Human) 4117, (Rat) 25677